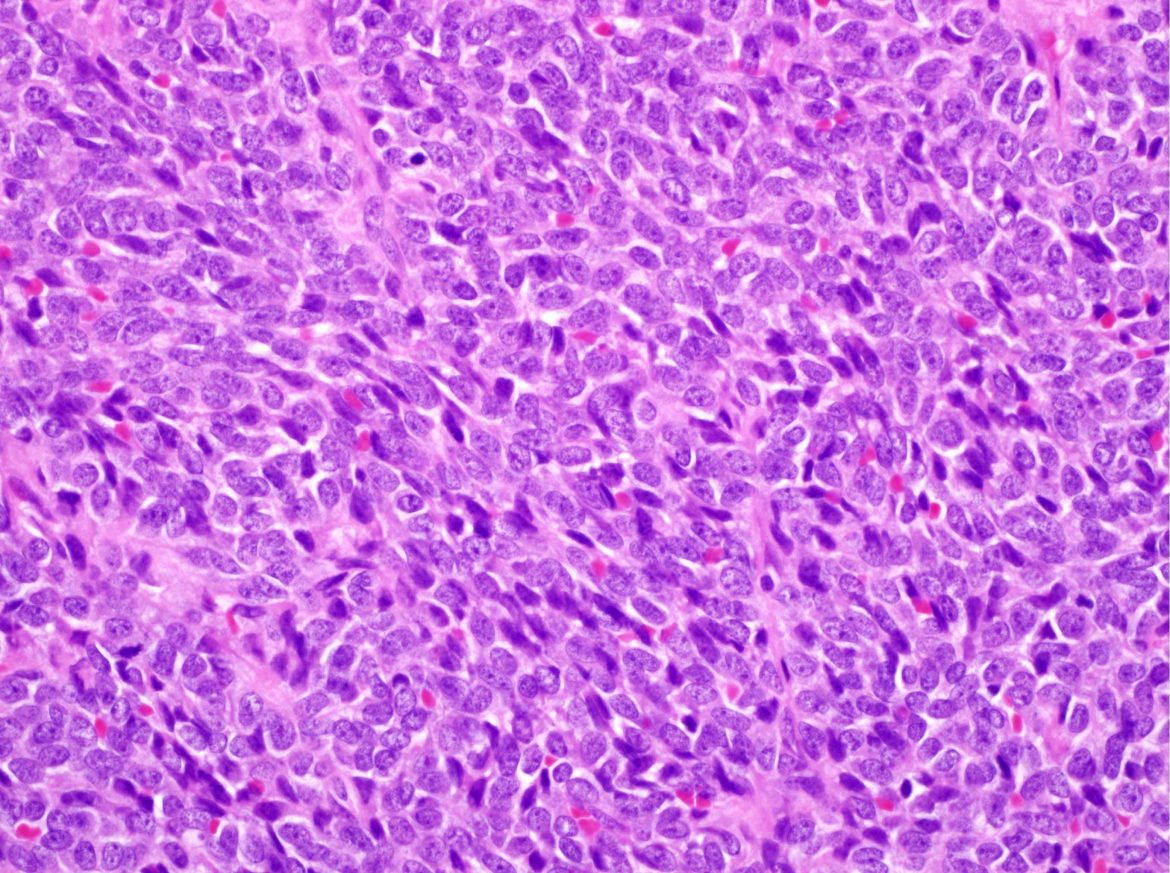

Tóm tắt ca lâm sàng
Sarcoma bao hoạt dịch là thể mô bệnh học hiếm gặp, chỉ chiếm dưới 0,1% các khối u ác tính vùng đầu cổ. Ca bệnh đầu tiên được báo cáo bởi BS. Jernstrom vào năm 1954. Thanh quản cũng là vị trí ít gặp nhất của sarcoma bao hoạt dịch.
Như hầu hết bệnh lý hiếm gặp khác, chiến lược điều trị tối ưu cho sarcoma bao hoạt dịch tại thanh quản vẫn chưa được hiểu biết một cách đầy đủ. Dựa trên các ca bệnh được báo cáo, phẫu thuật cắt bỏ rộng rãi +/- xạ trị bổ trợ thường là lựa chọn đầu tiên được xem xét. Vai trò của hóa chất vẫn còn là đề tài tranh luận.
Trong bài viết này, chúng tôi trình bày một ca bệnh chẩn đoán sarcoma bao hoạt dịch tại thanh quản, không có khả năng can thiệp ngoại khoa cắt bỏ, được chỉ định xạ trị tân bổ trợ kết hợp đồng thời hóa chất hàng tuần.
Một bệnh nhân nam giới, 22 tuổi, người Philippines, ECOG-PS 0, không có tiền sử bệnh lý và lạm dụng chất, đến viện sau 7 tháng khởi phát cảm giác dị vật vướng ở cổ họng. Sau đó, các biểu hiện khàn tiếng, tăng tiết dãi, nuốt khó với thức ăn rắn lần lượt xuất hiện. Gần nhất, triệu chứng khó thở buộc người bệnh đến viện thăm khám.
Người bệnh được tiến hành thủ thuật mở khí quản, đặt ống xông mũi dạ dày và sinh thiết mở qua thượng thanh môn với định hướng chẩn đoán ban đầu đến một tổn thương lành tính. Kết quả giải phẫu bệnh trả lời đây là khối u tế bào hình thoi ác tính (Hình 1).

Mặc dù ung thư biểu mô tế bào vảy dạng sarcoma là thể mô bệnh học được nghĩ đến đầu tiên như một chẩn đoán phân biệt, tuổi bệnh nhân và hình ảnh nhuộm hematoxylin – eosin (H&E) hướng nhiều hơn đến chẩn đoán sarcoma bao hoạt dịch. Xét nghiệm hóa mô miễn dịch nhiều dấu ấn được thực hiện để khẳng định chẩn đoán (Bảng 1, Hình 2).



Cộng hưởng từ đầu cổ với gadolinum phát hiện khối kích thước 10,4 x 7,6 x 5,1 cm (Đường kính trên dưới x Rộng x Trước sau) “án ngữ” ở phía sau khoang miệng, họng miệng và thanh quản (Hình 3A). Một vài hạch cổ kích thước dưới 1 cm cũng đã được ghi nhận. Một nốt 0,6 cm ở thùy trên phổi trái được mô tả với các đặc điểm nghĩ nhiều đến tổn thương viêm trên cắt lớp vi tính ngực.